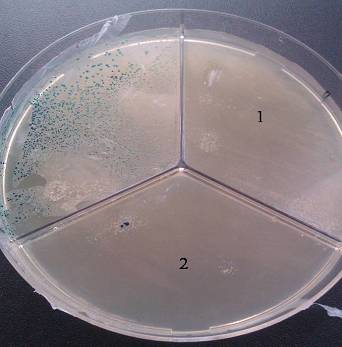

Инфекционные заболевания и заболевания, связанные с бактериями, являются причиной довольно значительной части смертей сельскохозяйственных птиц и животных. Некоторые из бактерий патогенны и для человека, их присутствие в продуктах питания может представлять опасность для его здоровья, а иногда – и жизни.
К актуальным для нашей страны возбудителям бактериальных инфекций птиц можно отнести Y. enterocolitica, Salmonella enterica, Avibacterium spp., Pasteurella spp., Listeria monocitogenes, Gallibacterium anatis, Lactobacillus salivarius (патогенные формы), Enterococcus cecorum, E.coli, Mycoplasma spp., Pseudomonas aeruginosa, Clostridium perfringens и многие другие [2, 5, 7]. Следует отметить, что большая часть перечисленных микроорганизмов не культивируется в лабораториях птицефабрик. Выделение и подтитровка на антибиотики культур кишечной палочки или стафилококков никак не могут заменить изоляцию всего многообразия этиологических агентов бактериальных инфекций.
С одной стороны, использование антибиотиков в животноводстве повышает риск попадания антибиотикоустойчивых микроорганизмов в организм человека с продуктами питания, а с другой – встает вопрос, не приведет ли ограничение потребления антибиотиков в животноводстве к росту заражения людей патогенными бактериями и повышению вероятности появления антибиотикоустойчивых штаммов. В этом случае возрастет потребление антибиотиков населением.
Из нашего опыта следует, что работа бактериологических лабораторий птицефабрик порой приносит больше вреда, чем пользы. Выделение не основной причины гибели птицы, а наиболее легко культивируемых микроорганизмов дезориентирует врача и приводит к назначению неактуальных антибиотиков. Кроме того, многие бактерии могут быть выделены только от живой птицы, и доставка проб биоматериала в посторонние лаборатории часто сопровождается гибелью притязательных микроорганизмов (пастерелл, возбудителей гемофилеза и орнитобактериоза). Из данных наблюдений вытекают два вывода:
- наиболее надежным критерием эффективности антибиотика является мониторинг результатов его применения на птицефабрике.
- на крупных птицефабриках лабораторно-диагностические лаборатории необходимо развивать до общемирового уровня и включать в выполняемые ими функции элементы научно-исследовательской работы.
Проблема развития антибиотикорезистентности по-прежнему стоит остро: мы регулярно выделяем полирезистентные, т. е. устойчивые к широкому спектру антибиотиков культуры E. coli и Salmonella spp., и ряду птицефабрик уже нельзя предложить антибиотик, обладающий достаточной активностью в отношении сальмонелл или кишечной палочки. Решение данной проблемы следует разбить на две части:
- профилактика возникновения антибиотикорезистентности и минимизация рисков распространения антибиотикорезистентных микроорганизмов включая их попадание в продукты птицеводства;
- терапия и профилактика заболеваний, вызванных антибиотикорезистентными бактериями.
Необоснованное применение антибиотиков и низкая их эффективность – повод для увеличения курсовых доз и кратности курсов лечения, а это, в свою очередь, ускоряет формирование устойчивых штаммов бактерий.
Мероприятия санитарного характера и биозащита предприятия – мощный фактор профилактики антибиотикорезистентности. Однако следует учитывать, что уничтожение устойчивых к антибиотикам микроорганизмов путем дезинфекции может быть недостаточным, важно разрушить и генетический материал, потенциально содержащий гены антибиотикорезистентности. К наиболее эффективным дезинфектантам, разрушающим ДНК, можно отнести персульфаты (Экоцид) (рис. 1.), хлорсодержащие антисептики и кислоты. Альдегиды, гуанидины и четвертичные аммонийные соединения не способны подавлять горизонтальный перенос генетических факторов устойчивости к антибиотикам [3].
Рис. 1. Подавление устойчивости к ампициллину путем разрушения плазмид с геном лактамазы. Результаты трансформации плазмиды pBlueskript, подвергнутой воздействию препаратов Экоцид (1) и HPPI (2), культуры E.coli XL Blue
На протяжении последних лет в секторе молекулярной биологии СФНЦА РАН часто выделяются культуры кишечной палочки и сальмонелл, устойчивые к широкому спектру антибиотиков (фторхинолонам, лактамам, аминогликозидам) именно на птицефабриках, предпринявших попытку тотального отказа от данных препаратов. Резистентность к антибиотикам у этих микроорганизмов реализуется с помощью эффлюкса – системы активного выброса токсичных ксенобиотиков (рис. 2, 3), к которым относятся и многие антибиотики (энрофлоксацин, гентамицин, хлорамфеникол, флорфеникол и др.).
Для активного выброса используется система насосов, запускаемых с использованием сложной системы регуляции в ответ на оксидативный стресс, действие некоторых дезинфектантов и положительно заряженных молекул. Так, например, микотоксин цитринин, продуцируемый микроскопическими грибами родов Penicillium и Aspergillus, обладает антибактериальной активностью, вызывает дисбиоз кишечника и, в отличие от антибиотиков, попадает в организм с кормом ежедневно. Наши исследования показали наличие активации эффлюкса у сальмонелл под действием цитринина.
Таким образом, качество кормов может оказаться даже более значимым фактором, влияющим на устойчивость микробиоты птиц к антибактериальным препаратам, так как нередко птицы потребляют микотоксины непрерывно и в существенно больших концентрациях, чем антибиотики.
Что касается терапии и профилактики заболеваний, вызванных антибиотикорезистентными бактериями, картина здесь следующая.
Во-первых, далеко не всегда мы видим корреляцию результатов подтитровки на антибиотики и клинической эффективностью последних. Размеры отечественных птицефабрик велики, уровень биозащиты и высокая культура производства способствуют ограничению спектра возбудителей бактериальных инфекций. Именно поэтому результаты ограниченных экспериментов с лекарственными препаратами можно смело экстраполировать на птичники.
Во-вторых, механизмы действия многих антибиотиков до конца еще не изучены [4]. Например, некоторые антибиотики способны активировать лизогенные бактериофаги (многие бактериальные клетки содержат в своем составе неактивные бактериофаги в виде профагов). Как следует из наших исследований, наиболее часто наблюдается активизация бактериофагов под действием сульфаниламидных антибиотиков, доксициклина, флорфеникола [4]. Возможно, необъяснимо высокая клиническая эффективность сульфаниламидных препаратов обусловлена именно этим фактором. В итоге представляется перспективным использовать препараты бактериофагов в качестве дополнительного фактора для борьбы с антибиотикорезистентными формами бактерий [6].
Высокую клиническую эффективность показали челночные схемы антибиотикотерапии. Например, 2–3 дня квестигин и 2–3 дня гентамицин или 3 дня флорон и 2 дня гиракса. Преимуществом таких схем является дополнительное подавление вторым антибиотиком бактерий, приобретших устойчивость к первому. При терапии кишечных инфекций нередко развивается постантибиотический дисбиоз. В такой ситуации дополнительное введение колистина обеспечивает пребиотический эффект и минимизирует риски реинфекции.
В подавляющем большинстве случаев массовые бактериальные инфекции развиваются на фоне инфекций вирусных. Из наших наблюдений следует, что разные вирусные агенты провоцируют разные вторичные бактериальные инфекции. Например, метапневмовирусная инфекция часто влечет за собой орнитобактериозы и пастереллезы. Эшерихиозы чаще возникают на фоне всплеска ИБК, ИЛТ, болезни Гамборо и НБ. Флавивирусная инфекция кур обычно провоцирует иерсиниозы [1].
Синдром везикулярного энтерита резко повышает риск развития кормовых бактериальных токсикоинфекций, энтерококковых инфекций и бактериального эндокардита, ассоциируемого с L. salivarius [7]. Наблюдаемый последние два года парвовирусный энтерит цыплят обычно ассоциируется с широким спектром вторичных бактериальных инфекций, плохо поддающихся антибиотикотерапии. Как правило, противодействие первичным вирусным инфекциям позволяет добиться лучшего клинического эффекта.
Однако птицефабрики с высоким уровнем сохранности часто отличаются от птицефабрик с меньшим уровнем сохранности эффективной биозащитой и высокой антагонистической активностью у птиц кишечной микробиоты, а не интенсивным потреблением ими антибиотиков.
Рис. 4. Кутикулиты вызванные флавивирусной инфекцией и очаговые поражения печени ассоциируемые с иерсиниозом
Колибактериоз (колиэнтерит, колисептицемия, колиперитонит, эшерихиоз) — опасное высоко контагиозное заболевание домашней птицы (кур, гусей, индюков) вирусной этиологии. Болезнь наносит колоссальный финансовый ущерб фермерским хозяйствам, крупным промышленным комплексам. Вспышки инфекции регистрируют во всех регионах нашей страны. Болезнь характеризуется стремительным развитием и, если не предпринять соответствующих мер, может стать причиной массового падежа всего куриного поголовья.
При острой форме инфекции 30–35% молодняка погибает в первые сутки. Если инфицированы взрослые курочки, у них снижается продуктивность. Поэтому основной задачей специалистов ветеринарной медицины является своевременное выявление очагов заболевания, проведение профилактических мер.
Пути заражения
Колибактериоз птиц, других видов домашней птицы провоцирует кишечная палочка (E coli). В естественной среде в большом количестве содержится в птичьих испражнениях (кале). Штаммы, которые провоцируют болезнь у домашних птиц, обладают высокой вирулентностью, токсикогенностью. Некоторые из них обладают гематолитическими свойствами. При благоприятных условиях во внешней среде кишечная палочка сохранит активность три–четыре месяца. Эшерихии неустойчивы к формалину, щелочам, действию некоторых химических дезсредств. При этом выдерживают минусовые температуры, замораживание, высушивание.
Заражение цыплят, курочек происходит аэрогенным, фекально-оральным способом, в случае употребления обсемененных кормов, употребления воды, загрязненной фекалиями, в которых содержится возбудитель инфекции. Основным источником колибактериоза является больная, переболевшая птица, латентные бактерионосители. В организме больной птицы эшерихии локализуются в органах респираторного тракта (воздушных мешках), а также в ЖКТ (кишечник, желудок).
Возможен трансовариальный способ инфицирования (через яйца), при котором новорожденные цыплята рождаются уже зараженными, сильно ослабленными или нежизнеспособными.
Переносчиками эшерихий может быть обслуживающий персонал. Патогенные бактерии содержаться на руках, одежде, инвентаре.
Инфицированию домашней птицы способствует несоблюдение санитарно-гигиенических норм, частые стрессы, ослабляющие организм пернатых подопечных, неблагоприятные условия в брудерах, птичниках, помещениях, в которых содержится молодняк, взрослые особи.
Причины, способствующие развитию колисептицемии:
- несоблюдение санитарных норм, правил;
- высокая влажность в птичниках;
- несбалансированный рацион;
- снижение резистентности организма;
- скученное содержание птицы;
- перегрев, переохлаждение птицы;
- содержание в одном помещении курочек различных возрастных групп, пород.
Важно! Породы мясных кроссов, цыплята бройлеры очень часто болеют колибактериозом. В специализированных бройлерных хозяйствах, если болезнь переходит в хроническую форму, от данной болезни погибает 40–45% куриного поголовья. Инфекция поражает индюшат, утят, гусят.
В группу риска попадают маленькие цыплята с неокрепшей иммунной системой, ослабленные, истощенные особи, курочки, которые переболели, болеют паразитарными, вирусно-инфекционными заболеваниями.
Симптомы и лечение
Продолжительность инкубационного периода составляет от нескольких часов до двух–пяти суток. Скорость, интенсивность проявления характерной для колибактериоза птиц симптоматики во многом зависит от следующих факторов:
- возраста, индивидуальных, физиологических особенностей;
- серотипа, вирулентности, количества возбудителя в организме пернатых;
- степени иммунной защиты, состояния резистентности организма;
- локализации эшерихий.
Важно! У цыплят, птенцов инфекция протекает преимущественно остро, подостро. У взрослых особей отмечают хроническое течение болезни. Колибактериоз у бройлеров имеет острое, хроническое течение.
Среди основных симптомов колисептицемии можно выделить:
- резкое повышение общей температуры;
- ухудшение общего состояние, вялость, апатия;
- снижение, отсуствие аппетита;
- нарушение в работе органов пищеварительного тракта;
- сильная жажда;
- потеря массы тела;
- снижение продуктивности;
- нарушения в работе ЦНС;
- конъюнктивиты, кератоконъюнктивиты;
- бледность гребешков, сережек, слизистых;
- пенистая желая, желто-зеленая диарея.
Если поражена респираторная система, у птицы затрудняется дыхание. Отмечают одышку. Дыхание становится учащенным, прерывистым. Цыплята бройлеры выглядят истощенными, отстают в росте от своих здоровых сородичей. При острой форме птенцы чихают, кашляют. Из клюва, глаз выделяется слизистый экссудат.
При хронической форме инфекции эшерихии локализуются в ЖКТ. Бактерии нарушают целостность слизистых, провоцируют острое воспаление, поражают яйцевод и могут спровоцировать атрофию яичников. Птицу мучает изнуряющая профузная диарея. Испражнения водянистой консистенции, пенистые, зеленоватого цвета. У водоплавающих птиц болезнь проявляется нервными расстройствами различной степени тяжести.
Как правило, гибель инфицированной птицы наступает на 10–15-й день. Выздоровевший молодняк в дальнейшем плохо развивается, и некоторое время является основным источником инфекции.
Диагностика и лечение колибактериоза
Лечить колибактериоз нужно незамедлительно, заметив первую характерную симптоматику для данной инфекции. Только так можно избежать массового падежа домашней птицы. Лечебную терапию при колисептицемии у кур должен назначать ветеринар, исходя из результатов диагностических, лабораторных исследований.
При постановке диагноза учитывается эпизоотологическая ситуация в регионе, данные анамнеза, клинические проявления, результаты дифференциальной, посмертной диагностики.
В лечебной терапии, при колибактериозе у кур, применяют комплексные антибактериальные препараты системного действия (левомицетин, фурагин, полимексин, фармазин, цефтазидим, неомицин, антибиотики тетрациклинового, цефалоспоринового ряда).
Лечение колисептицемии у курочек проводится несколькими курсами. В лечебной терапии применяют нитрофураны, сульфаниламиды. При необходимости, после 5–7-ми суточного интервала, лечение возобновляют.
После завершения курса антибиотикотерапии, на протяжении пяти–семи дней с целью нормализации кишечной микрофлоры птенцам, курочкам, бройлерам дают пробиотики, ферментные препараты, средства гомеопатии.
Помимо лечения медикаментами, обязательно проведите обработку помещений, курятников, используя дезсредства (хлорскипидар, раствор диоксина из расчета 1 мл на 1м 2 площади).
Профилактика
Иммунитет при колисептицемии — пассивный, передается через яйцо от вакцинированных матерей и сохраняется в течение одной–трех недель, активный — до трех–трех с половиной месяцев. У цыплят формируется после проведения профилактической иммунизации. Для вакцинации кур применяют специфические эшерихиозные антигены.
При убое домашней птицы необходимо тщательно осмотреть тушки, при наличии патологоанатомических изменений или истощения их уничтожают.
Чтобы избежать заражения курочек эшерихиями, создайте пернатым подопечным идеальные условия, соблюдайте санитарные нормы, ветеринарные нормы при инкубации яиц. Рацион птенцов должен быть питательным, витаминизированным, разнообразным. Птенцам со второй недели жизни можно давать витаминизированные корма, минеральные прикормки.
Внимательно следите за состоянием здоровья пернатых подопечных. С лечебно-профилактической целью здоровой птице можно выпаивать раствор фурацилина в течение 7–9 суток. Можно подмешивать к кормам левомицетин на протяжении недели (50 мг на килограмм живой массы).
В случае ухудшения состояния, проконсультируйтесь с ветврачом относительно выбора лечебной терапии.
Новикова О.Б., к.в.н., Зав. Отделом микробиологии ВНИВИП — филиал ФНЦ ВНИТИП РАН
С. Орлов, технический специалист отдела по работе с ключевыми клиентами, птицеводство и диагностика, Зоэтис
Колибактериоз является распространенной и затратной болезнью птиц бактериальной этиологии в птицеводческих хозяйствах промышленного типа.Escherichiacoli присутствует практически на всех птицеводческих предприятиях, большинство штаммов не патогенно и находится в кишечном тракте в качестве комменсалов.Те штаммы, что вызывают заболевания, зачастую не только колонизируют кишечник, но и адаптировались к тому, чтобы жить за пределами кишечного тракта, что ведет как к локализованным, так и системным проявлениям заболевания. Это один из наиболее значимых бактериальных патогенов, обнаруживаемых у цыплят первой недели жизни и приводящий к проблемам на протяжении всего жизненного цикла поголовья, включая ухудшение производственных показателей, разнородность стада и увеличение падежа [1][2].
Наиболее частыми проявлениями для родстада бройлеров и коммерческой несушки включают септицемию, перитониты и сальпингиты; у коммерческих бройлеров аэросаккулиты и септицемия, целлюлиты и воспалительные процессы приводят к отбраковке тушек. Так же встречается синдром опухшей головы у бройлеров и реже у родстада[3][4][5].
Экономический ущерб, причиняемый колибактериозом, весьма значителен и определяется он гибелью эмбрионов и цыплят, снижением привесов и яйценоскости, неудовлетворительным развитием переболевшего молодняка. Взрослые куры редко болеют колибактериозом в клинической форме, но в кишечнике их могут персистировать патогенные варианты кишечной палочки и усиление любого предрасполагающего фактора, при отсутствии специфического иммунитета, влечет за собой развитие заболевания[3].
Колибактериоз у птиц – это системная вторичная (секундарная) инфекция, возникающая при иммунодепрессивном состоянии птицы, а также при вирусных болезнях, связанных с поражением респираторного тракта.
Колонизация возбудителя в тонком кишечнике — значимый этап развития колибактериоза любой формы. Эшерихии с помощью адгезивных антигенов прочно связываются с ворсинками слизистой кишечника, и их нельзя устранить механическим путем. В патогенезе болезни адгезивные антигены эшерихий играют ведущую роль, большое значение имеют и токсины, которые накапливаются в кишечнике. Высокая восприимчивость птицы к колибактериозу связана с физиологической незащищенностью тонкого отдела кишечника против колонизации эшерихиями [3].
Доминирующая роль E.coli в инфекционной патологии птиц значительно осложняет эпизоотическую ситуацию в хозяйстве вследствие того, что кишечная палочка является фундаментом для развития смешанных инфекций. Колибактериоз часто протекает в ассоциации с пастереллёзом, гемофилёзом, стафилококкозом. Особенно ощутимый ущерб наблюдают при сочетанном течении колибактериоза и микоплазмоза[3][5].
Анализ спектра микрофлоры, выделенной в течение последних лет от птиц разных видов из разных объектов в хозяйствах различного технологического направления, убедительно показывает доминирующую роль кишечной палочки, удельный вес которой составляет 41,2%. На долю другой кишечной микрофлоры приходится 24%, и кокковой микрофлоры – 26%[3].
Научными сотрудниками ВНИВИП Новиковой О.Б. с соавторами в 2016 году было изучено выделение E.coli из различных органов павшей птицы. Культуры E. coli были выделены из сердца, легких, печени, селезёнки, почек и желточных фолликул. Выделение кишечной палочки из желточных фолликул указывает на возможный трансовариальный путь передачи инфекции.
У выделенных культур изучали вирулентные свойства на моделях заражения развивающихся куриных эмбрионов (РКЭ) 7-8-дневного срока инкубации, интраорбитального заражения цыплят первых дней жизни и на моделях внутривенного и внутримышечного заражения 60-дневных цыплят или взрослых кур.
Вирулентные культуры E.coli вызывали гибель эмбрионов в течение 24-48 часов (фото 1), а цыплят первых дней жизни — в течение 24-72 часов с признаками острого сепсиса (серозный перикардит и геморрагический дуоденит).
Фото 1. Гибель эмбриона вследствие воздействия вирулентной культуры E. coli.
У цыплят более старшего возраста отмечали длительное течение болезни с патологоанатомическими признаками фибринозного перикардита и перигепатита (фото 2).
Фото 2. Фибринозный перикардит и перигепатит, вызванныеE. coli.
При внутримышечно заражении наблюдали обширный разлитой некроз на месте введения культуры (фото 3).
Фото 3. Обширный разлитой некроз на месте введения культуры вирулентной E. coli
От павших эмбрионов, а также от цыплят из крови сердца и печени выделяли исходные культуры заражающего штамма.
При заражении слабовирулентными культурами кишечной палочки цыплят первых дней жизни отмечали отставание в росте и развитии по сравнению с контрольными незаражёнными (фото 4)[3].
Фото 4. Отставание цыпленка, пораженного вирулентным штаммом E. coli, в росте и развитии в сравнении с незараженным контролем.
Снижение присутствия E. coli инфекции за счет вакцинации.
Опосредованно снизить риск развития колибактериоза возможно за счёт устранения воздействия предрасполагающих факторов, прежде всего борьбой с первичными респираторными заболеваниями, включая Ньюкаслскую болезнь, инфекционный бронхит, ларинготрахеит, микоплазмоз и иммуносупрессивными вирусными инфекциями — инфекционной бурсальной болезнью, анемией цыплят, болезнью Марека. В дополнение, необходимо контролировать иные факторы, которые так же влияют на развитие заболевания,– стресс, связанный с нарушением температурного режима содержания, вентиляцией, микотоксинами, загрязнением питьевой воды[5].
В ряде стран для борьбы с колибактериозом до сих пор широко применяются антибиотики, однако потеря их эффективности требует поиска иных решений. В некоторых странах использование антибиотиков ограничено на законодательном уровне, но даже если подобных ограничений нет – препятствием является резистентность возбудителя к терапевтическим агентам. Становится очевидным, что для решения проблемы колибактериоза целесообразно использовать вакцины, специально разработанные для стимуляции иммунного ответа против патогенныхE. coli в качестве естественного дополнения программы вакцинации против первичных респираторных и иммуносупрессивных патогенов. В дополнение, отказ от постоянного и чрезмерного использования антибиотиков улучшит качество продукции для потребителя и снимет нарекания со стороны контролирующих органов.
Достижения в молекулярной биологии позволили создать вакцинный штамм, эффективный против колибактериоза, который стал основой для коммерческой вакцины Пулвак E. coli. Данная вакцина стимулирует оба типа иммунитета: тканевой (клеточный) и гуморальный (циркулирующие антитела)[5].
Пулвак E. coli представляет собой лиофилизированный порошок для приготовления суспензии. Содержит в своем составе бактерию E. coliштамм EC34195, серотипа О78, которая не имеет факторов патогенности, вызывающего заболевание, что делает возможным её применение в качестве вакцины. Применяется методом крупнокапельного спрея или выпойкой.
Вакцина полностью апатогенна, она не сохраняется в птице и окружающей среде сколь либо длительный период времени. Особенность вакцинального штамма не допускает invivo размножение, он оставляет после себя лишь активированные макрофаги, готовые вступить в борьбу с патогенными штаммами E. coli[1].
В дополнение, Пулвак E. coli совместим с кокцидиостатиками и вакцинами против ИБК и НБ [5].
Применение Пулвак E. coli на родстадах и товарной несушке.
На молодке и несушках применимы живые и инактивированные вакцины. Не зависимо от типа используемой вакцины, клиническое заболевание, вызываемое E. coli инфекцией, менее выраженно проявляется у вакцинированной в сравнении с не вакцинированной птицей.
· Обеспечивает защиту только от гомологичных E. coli штаммов
· Нет перекрестной защиты
· Инъекция в грудку
· Снижение заболеваемости и падежа из-за E. coli инфекции
Коммерческая живая модифицированная
· Пулвак E. coli 078 (Зоэтис)
· Перекрестная защита от О1, О2 и О18
· Снижение заболеваемости и падежа из-за E. coli инфекции
· Повышение продуктивности птицы
Обзор мировой литературы свидетельствуют о глобальной актуальности проблемы колибациллеза у родстад и промышленной несушки, ниже приведены свидетельствапрактиков и мнения международных экспертов.
E. coli инфекция влечёт за собой ряд проблем, в числе которых перитониты и сальпингиты, снижение продуктивности и увеличение падежа или поражений, приводящих к выбраковке. Применение Пулвак E. coli обеспечивает не только лучшую сохранность и продуктивность птицы, но и уменьшает вертикальную передачу возбудителя.
Дионн Рауф из лаборатории Дельтамун, Южная Африка, указал навозрастающую проблему передачи E. coli от родстада к потомству. Применение антибиотиков на бройлерах не достаточно эффективно, потому что повышенный падёж отмечается уже в первые дни после инкубации.
Кроме того, серотипирование E. coli не получило широкого распространение в Южной Африке, по этому при иммунизации птицы очень важно обеспечить перекрёстную защиту.
По наблюдениям Ван Билджона, период с 22 по 32 неделю для родстада бройлеров является особо стрессовым, что способствует развитию E. coli инфекции. В ходе этого периода птица не только активно набирает массу, но и выходит на яичную продуктивность с 0% до примерно 89%.
В дополнение, птице необходимо адаптироваться к новой среде обитания ввиду перевода из помещения для реммолодки в зал для содержания взрослой птицы. Стресс от начала продуктивного периода усиливается за счёт изменения светового режима и смены рациона. Возрастает риск развития перитонитов и сальпингитов, вызываемых E. coli.
Вакцинация родительских стад бройлеров против E. coli позволяет получать более здоровое потомство, отмечают специалисты из Южной Африки
У цыплят от вакцинированного родстада падёж в 7 дней составил 1,18% в сравнении с 1,44% у цыплят от невакцинированной птицы. Вакцинация так же способствовала увеличению веса цыплят, который составил 188 г в 7 дней в сравнении с 183 г у цыплят, полученных от невакцинированной птицы.
С января 2011 Ван Билджон для защиты бройлерного родстада и их потомства от E. coli инфекции использует Пулвак E. coli, заменив данной вакциной применявшийся ранее инактиват.
В сравнении с инактивированной вакциной, живая вакцина менее затратна и не даёт побочных эффектов, отмечает Ван Билджон.
Схема вакцинации против E. coli может отличаться на различных фермах, использование живой вакцины в раннем возрасте, например, может дополняться последующей вакцинацией инактиватом в продуктивный период.
Вакцина не является магическим средством, которое избавляет от необходимости осуществлять надлежащий уход за птицей и обеспечивать биобезопасность, но позволяет увеличивать прибыльность за счёт минимизации негативного влияния E. coli, подчеркивает Аллен Болл, эксперт государственной ветеринарной практики Великобритании [10].
С точки зрения экономики предприятия, в качестве примера, доктор Симон М. Шейн приводит случай, когда колибактериоз являлся причиной 10% падежа в стандартной ферме по содержанию родстада бройлеров с 20 до 65 недель. Из-за инфекции среднее ожидаемое количество цыплят на несушку сокращалось с 125 до 110 цыплят. Для того, чтобы обеспечить получение 100000 цыплят в неделю, необходимо прибавлять 3000 несушки к имеющимся 30000. Затраты, связанные с содержанием дополнительной птицы (от выращивания реммолодки до содержания несушек), составляло € 40000 в год. Стоимость двукратной обработки вакциной Пулвак E. coli — €420 в год. Если за счёт вакцинации сократить 50% потерь от падежа ассоциированного с колибактериозом, соотношение выгоды к затратам составит 50:1 [5].
В другом исследовании, в США, вакцина применялась на коммерческой несушке с суточного возраста, с ревакцинацией в 12 недель* с заражением E. coli на 23 неделю. Опыт показал снижение падежа на 13 % по сравнению с птицей из не вакцинированного контроля.
В стаде с 75000 несушек подобное снижение падежа означает, что 3000 голов были спасены от падежа, что дало дополнительно 900000 яиц.
В США, где Пулвак E. coli доступен на рынке в течение 11 лет, полевой опыт показал значительные выгоды. На среднем Западе у несушек 50 недельного возраста в среднем падеж составлял 2,31%, и был понижен до 1,51% трёхкратной дозой вакцины.* На Востоке Соединенных Штатов падёж среди поголовья, в сравнении с уровнем падежа за предыдущие пять циклов выращивания, снизился с более чем трёх процентов до одного процента.
Полевые испытания в США с более чем 300000 голов родительского стада бройлеров, вакцинированных перед периодом яйцекладки, показали снижение падежа с 2,8% до 1,9%, и только двум стадам из 28 потребовалась антибиотикотерапия, в сравнении с 13-ю из 28 не вакцинированных стад [1].
*Важно отметить, что в данных исследованиях, осуществленных в США, назначалась более чем 1 доза вакцины, график вакцинации был откорректирован ветеринарным врачом.
Применение Пулвак E. coli на бройлерах.
Полевые опыты продемонстрировали успех вакцины в защите от различных гетерогенных серотипов на бройлерных фабриках в США, в истории которых отмечались проблемы с E. coli, показывая, что определение серотипов не критично для эффективной вакцинации [1].
Потенциал Пулвак E. coli был продемонстрирован в опыте, осуществлённом в Университете Оберна. При экспериментальном подкожном заражении, провоцирующем развитие целлюлита, вакцина на 16% снизила негативное влияние инфекции на привесы, на 32% уменьшила проявление общего колибациллёза, на 51% падеж и на 60% индекс целлюлитных поражений [5].
В полевых испытаниях в Джорджии на бройлерах более четырёх миллионов голов были вакцинированы в инкубаторе Пулвак E. coli. У вакцинированной птицы была лучше конверсия корма (1,79 против 1,84 у контроля) и со снижением уровня загрязнения на линии забоя с 1,22% до 0,73%, снижение затрат составило 0,51 цент на кг живого веса.
На другом испытании на бройлерах с участием более чем двух миллионов голов птицы в Арканзасе, сохранность улучшилась с 95,20 до 95,77 процентов и конверсия корма улучшилась с 1,95 до 1,90, что дало экономию 0,45 центов на кг живого веса [1].
Суммируя данные от использования Пулвак E. coli на 2 миллионах бройлеров в проблемной по E. coli птицефабрике в сравнении с 2 миллионами не вакцинированных бройлеров в аналогичных условиях откорма, получены следующие результаты: вакцина обеспечила 40% защиту против септицемии и 63% против аэросаккулитов. Индекс целлюлитных поражений снизился на 58%[5].
Полевой опыт из Марокко, получен из 15 ферм на 112000 бройлерах, вакцинированных Пулвак E. coli в инкубаторе или в первый день жизни на ферме, и сопоставлен с иными 112000 головами, выращенными на тех же фермах в качестве не вакцинированного контроля.
У вакцинированной птицы были лучше показатели по всем исследуемым параметрам. Падеж составил 7,7% против 8,8 у не вакцинированного контроля, проявления колибациллёза 1,7% против 3,5%. Среднесуточный привес увеличился с 59 до 61,3 граммов, в то время как конверсия улучшилась с 2,20 до 2,16.
Также у вакцинированной птицы значительно снизилась необходимость в антибиотикотерапии – 0,54 лечебных дня, в сравнении с 1,97 у контроля.
Применение Пулвак E. coli на индейке.
Индейка в высокой степени подвержена колибациллёзу, особенно в присутствии предрасполагающих факторов, присутствующих практически на каждом предприятии – вирус геморрагического энтерита и иммуносупрессивных агентов.
Доктор ветеринарной медицины Тура Бру и её коллеги осуществили опыт по использованию Пулвак E. coli на SPF индейке, с применением вакцины в возрасте 1 и 21 день. В опыте участвовало 80 голов, половина из которых получила вакцину. В последствии обе группы были заражены вирулентным O78 штаммом и содержались совместно. В первые 2 дня после заражения от колибациллёза пало 56% невакцинированной и 35% вакцинированной птицы.
В течение 7 дней из выживших голов 61,5% невакцинированной и 34,4% вакцинированной птицы имели выраженную клинику или пали от колибациллеза.
Опыты в Германии показали высокую степень защиты индейки, вакцинированной Пулвак E. coli методом крупнокапельного спрея, против интратрахеального заражения полевыми вирулентными штаммами E. coli.Использование Пулвак E. coli на индейке позволяет не только выращивать более здоровое поголовье, но и снизить использование антибиотиков [12].
Читайте также: